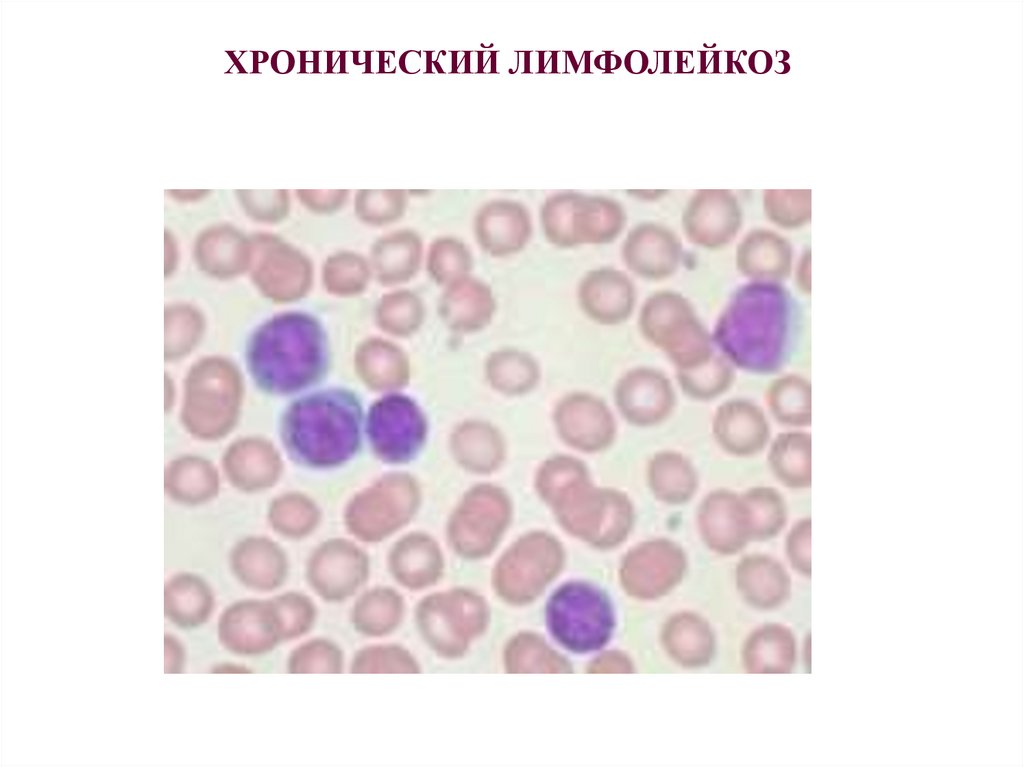

Похожие презентации:
Хронический лейкоз
1.
Хронический лейкоз2.
ХРОНИЧЕСКИЙ МИЕЛОЛЕЙКОЗ1-2 на 100 тыс. населения
Чаще мужчины, чаще лица пожилого возраста
Генетический компонент этиологии (филадельфийская
хромосома)
3.
ХРОНИЧЕСКИЙ МИЕЛОЛЕЙКОЗ:диагностика
Тромбоцитоз
Нейтрофилёз
Базофильно-эозинофильная ассоциация
Анемия
Спленомегалия
Общие симптомы
4.
ХРОНИЧЕСКИЙ МИЕЛОЛЕЙКОЗ:диагностика
Критерии ВОЗ:
10-19% миелобластов в крови или костном мозге
Более 20% базофилов в крови или костном мозге
Тромбоциты более 1000
Обнаружение филадельфийской хромосомы
Увеличение селезёнки
5.
Филадельфийская хромосома6.
ХРОНИЧЕСКИЙ МИЕЛОЛЕЙКОЗ:диагностика
Кровь
Костный мозг
Костный мозг
7.
ХРОНИЧЕСКИЙ МИЕЛОЛЕЙКОЗ:диагностика
Бластный криз
Более 20% миелобластов или лимфобластов в крови
или костном мозге
Развитие хлором (экстраоссальных очагов
лейкемоидной инфильтрации)
8.
ХРОНИЧЕСКИЙ МИЕЛОЛЕЙКОЗ:лечение
9.
ХРОНИЧЕСКИЙ МИЕЛОЛЕЙКОЗ:лечение
10.
11.
ХРОНИЧЕСКИЙ ЛИМФОЛЕЙКОЗ12.
ХРОНИЧЕСКИЙ ЛИМФОЛЕЙКОЗСамая распространённая форма лейкоза
75% новых случаев диагностируется у лиц старше 75 лет
Ежегодно более 7000 новых случаев в США
13.
В-лимфоцит14.
15.
ХРОНИЧЕСКИЙ ЛИМФОЛЕЙКОЗ:лечение
Химиотерапия
Радиотерапия
Биологическая терапия
Трансплантация костного мозга
16.
Ростовский государственный медицинский университетКафедра внутренних болезней № 1
Острый лейкоз
Батюшин М.М.
17.
ОСТРЫЙ ЛЕЙКОЗОстрый миелобластный
Острый промиелоцитарный
Острый миеломоноцитарный
Острый моноцитарный
Эритромиелоз
Острый мегакариоцитарный
18.
ОСТРЫЙ ЛЕЙКОЗ19.
ОСТРЫЙ ЛИМФОБЛАСТНЫЙЛЕЙКОЗ
Лихорадка
Геморрагический синдром
Гепатоспленомегалия
Лейкемоидные инфильтраты
Общие симптомы
Лимфаденопатия
Гиперлейкоцитоз более 100 * 109/л
Более 30% бластных клеток в костном мозге
20.
ОСТРЫЙ МИЕЛОБЛАСТНЫЙЛЕЙКОЗ
2,4 на 100 тыс. населения
12,6 на 100 тыс. населения старше 65 лет
21.
ОСТРЫЙ МИЕЛОБЛАСТНЫЙЛЕЙКОЗ
Лихорадка
Геморрагический синдром
Гепатоспленомегалия
Лейкемоидные инфильтраты
Общие симптомы
Лимфаденопатия
Гиперлейкоцитоз более 100 * 109/л
Более 30% бластных клеток в костном мозге
22.
ЛЕЙКОЗ:5-летняя выживаемость
О. лимфобластный лейкоз - 65,2% - взрослые, 90,5% - дети
Хр. лимфолейкоз – 74,2% - взрослые
О. миелолейкоз – 20,4% - взрослые, 53,1% - дети
Хр. миелолейкоз – 42,3% - взрослые

Медицина
Медицина








